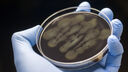
Campylobacter bacteria being examined in a dish

Coronavirus research: Food security, energy and supply chains
Experts from the Institute for Sustainable Food and Energy Institute are working with industry partners to understand the fragility in our supply chains and collaborate on ways to improve food security for all.

Our latest research
Podcast series: Coronavirus, Examined
We live in a world that is facing one of its biggest challenges in living memory. The coronavirus pandemic has devastating potential as it sweeps across the globe. To fight this virus and slow its spread, we've had to change almost everything about how we live our lives.
In Coronavirus, Examined we talked to experts from the University of Sheffield to explore the different ways in which coronavirus is changing our world and the way we live.
Our Coronavirus, Examined podcast
Contact
If you have any questions, please get in touch with our media team.